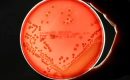

Category: Insight

Dua Pedang Romawi Langka Ditemukan di Situs Vila Kuno di Gloucestershire
Dua pedang kavaleri Romawi yang sangat langka berhasil ditemukan oleh seorang pendeteksi logam pemula dalam ekspedisi keduanya ...
Potensi Besar Jelantah Indonesia dan Tantangan Menuju Energi Terbarukan
Minyak jelantah atau minyak goreng bekas atau minyak jelantah — selama ini kerap dianggap limbah tak bernilai. Namun, siapa ...
Ketentuan Label Kadaluarsa pada Produk Makanan Menurut Peraturan Pemerintah
Salah satu hal penting yang harus diperhatikan dalam produk pangan adalah label masa kedaluwarsa. Tak sedikit ...
China Kembangkan Varietas Padi yang Sehat untuk Jantung
Tim peneliti dari China berhasil mengembangkan varietas padi baru yang diklaim sehat untuk jantung, karena padi ini mampu menghasilkan koenzim ...
Kini Usaha Budidaya Lobster Lebih Menjanjikan, Cacing Tanah Bisa Jadi Pakan Ramah Lingkungan
Usaha budidaya lobster kini akan lebih menjanjikan, setelah seorang peneliti di bidang Bioindustri Laut dan Darat dari Badan Riset ...
Jejak BTN dari Masa ke Masa, Hidup Mati di Zaman Kolonial hingga Berpeluang jadi Mega Bank di Indonesia
KEPRIMOBILE.COM – Perjalanan panjang Bank Tabungan Negara (BTN) menjadi salah satu institusi keuangan terkemuka di Indonesia tidak terlepas ...
Belajar dari Pelajaran dari Krisis 1998, Begini Cara Habibie Atasi Krisis hingga Rupiah Mampu Taklukkan Dolar
Beberapa waktu terakhir, nilai tukar rupiah kembali menunjukkan pelemahan terhadap dolar Amerika Serikat (AS). Pada 21 November 2024, ...


